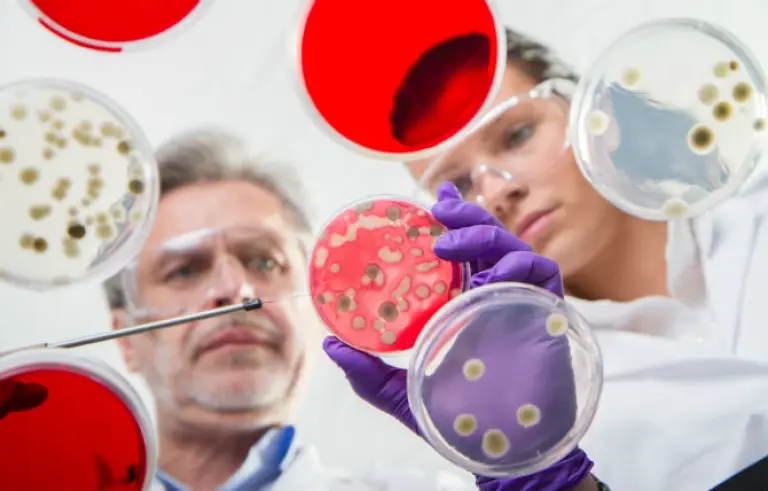
main image

Lectura 4:00 min
¿Qué es un microbioma?
Este año nos científicos pusieron especial énfasis en este sistema, y lo consideran el nuevo paradigma de la bilogía y la medicina.
Foto: Shutterstock
Uno de los paradigmas más importantes del siglo XXI para las ciencias biológicas y la medicina es el descubrimiento del microbioma, un universo de microorganismos, muchas veces simbióticos, que son parte de todos los organismos multicelulares (humanos, animales y plantas) que no pueden considerarse ya como entidades independientes.
Dentro de este universo se debe incluir a los millones de seres microscópicos que conviven con los humanos. Estos seres multicelulares son lo que llamamos la microbiota. Es la comunidad de microorganismos que viven sobre y dentro de nosotros. “Antes consideramos a estos organismos como patógenos, enemigos nuestros, y hemos descubierto que no necesariamente es así”, indicó Alejandro Frank, coordinador del Centro de Ciencias de la Complejidad (C3) de la Universidad Nacional Autónoma de México (UNAM), miembro de El Colegio Nacional y de la Academia Mexicana de Ciencias (AMC).
La palabra microbioma se refiere a los microorganismos y también a sus genomas, a su información genética y a la interacción entre este genoma molecular y el de los humanos; es decir, “se ha encontrado que es imprescindible tomar en cuenta a estos genes microbianos en nuestro funcionamiento e incluso en nuestra herencia y evolución”.
Los insectos aventajan a los humanos
Mientras se sabe que en humanos el microbioma se hereda a través del nacimiento vía vaginal, en el útero y la lactancia, esto no funciona igual en todos los animales. Esperanza Martínez Romero, del Centro de Investigación en Ciencias Genómicas e integrante de la AMC, apuntó que los koalas, por ejemplo, tienen una dieta basada en hojas de eucalipto, el cual es muy tóxico y difícil de digerir, por lo que tienen que transferir a sus crías las bacterias que les permitan degradar el alimento, y esto ocurre cuando sus pequeños cuentan con algunos meses de edad, a través de paps, heces fecales líquidas que los koalas comen.
La investigadora agregó que son los insectos los que llevan una significativa delantera, no solo desde el punto de vista metabólico, sino también en la manera de trasmitir la microbiota a su descendencia. Recordó el artículo “Capsule-transmitted gut symbiotic bacterium of the Japanese common plataspid stinkbug, Megacopta punctatissima”, reportado por investigadores japoneses, en el cual señalan que los insectos de la especie Megacopta punctatissima son un tipo de chinche que transmiten la microbiota intestinal de manera encapsulada; estas capsulas las colocan junto con sus huevos y cuando estos eclosionan, los insectos comen lo que parecen pequeñas heces fecales.
Pero los insectos tienen otras formas de transmitir las bacterias, las cuales se van a los ovarios y una vez allí se pegan a los huevos ya fertilizados. Así, cuando los nuevos insectos nacen ya llevan su paquete de células bacterianas, un mecanismo que los humanos no poseen.
Mientras los humanos tienen en el intestino un “zoológico de todos colores y formas”, los insectos cuentan con una selección. “Es lo que nosotros queremos hacer con todos los años de investigación y el dinero invertido en ciencia, seleccionar bacterias muy buenas que nos beneficien y no tengan que estar compitiendo con toda una gama de bacterias que pueden producir toxinas”, dijo Martínez Romero.
La revolución del microbioma es nueva porque su avance está basado en la tecnología de secuenciación que se hizo muy eficiente, barata y masiva. La posibilidad de secuenciar casi todo, desde gatos, perros, lagartijas, heces fecales o intestinos, ha llevado a generar gran cantidad de información del genoma y permitido el avance de la metagenómica.
“Hay nuevas hipótesis para explicar la diversidad del microbioma, incluso ya se habla de un nuevo concepto conocido como el holobionte; es decir, el individuo más sus bacterias”, subrayó la científica y recordó que este concepto “ha sido discutido por los científicos como Ford Doolittle, ecólogo microbiano que en este 2017 dijo que para entender el microbioma intestinal es necesario pensar que es la canción y no el cantante lo que importa: la canción es la función de las bacterias y el cantante las bacterias”.
Con información de la AMC